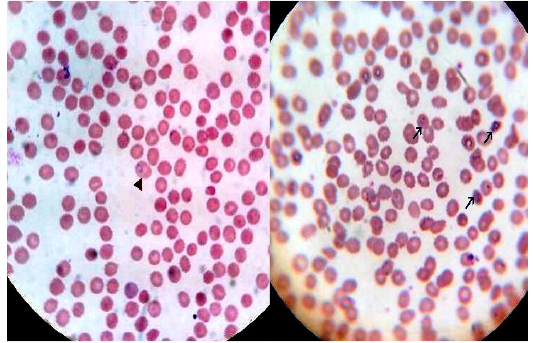
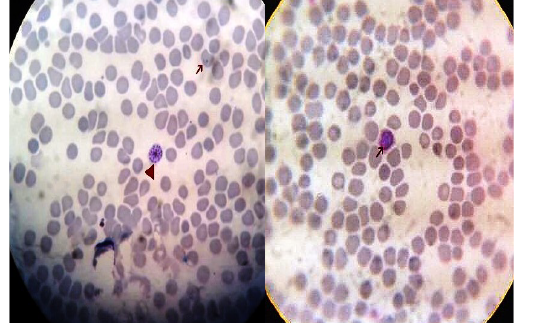

The Journal of Advances in Parasitology
Thick blood film stained with Lieshman stain showing Plasmodium falciparum ring stages with magnification power 100x.
Thick blood film stained with Lieshman stain showing Plasmodium falciparum ring (long arrows) and gametocytes stages(short arrows) with magnification power 100x
Thick blood film stained with Lieshman stain showing Plasmodium vivax ring and trophozoites stages with magnification power 100x
Thin blood film stained with Lieshman stain showing Plasmodium vivax ring stages with magnification power 100x
Thin blood film stained with Lieshman stain showing Plasmodium vivax gametocytes (long arrows) and shizonts (short arrows) with magnification power 100x